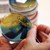
Нов супермикроб в сърцето на Европа

Непознати микроби се появяват от топящите се ледници
- Редактор: Виктория Христова
- Коментари: 0

Новите микроби трябва да бъдат изследвани и да бъдат идентифицирани потенциални патогени, заявяват учени
Топящите се ледници разкриват стотици хиляди тонове бактерии, показва ново изследване, цитирано от „Гардиън”. Микробите, освобождавани в световния океан, може да обогатят екосистемите, но трябва да бъдат внимателно изследвани, за да бъдат идентифицирани потенциални патогени, предупреждават учените, съобщава БТА.
Бързото топене на ледовете заради климатичната криза показва как ледниците и уникалните микробни екосистеми, които ги обитават, "умират пред очите ни", посочват учените. Те са в надпревара с времето да изследват тези екосистеми, преди да изчезнат.
Резултатите от проучването са публикувани в специализираното издание "Nature Communications Earth and Environment Journal".
Някои от тези микроби биха могли да са и бъдещ източник на полезни биологични молекули като нови антибиотици например. Учените са събрали повърхности стопени води от осем ледника в Европа и Северна Америка и от две места в ледената покривка на Гренландия. Във всеки милилитър вода са открити десетки хиляди микроби. По оценки на специалистите освобождаваните от стопените ледове бактерии и водорасли ще добавят средно около 650 000 тона въглерод годишно за следващите 80 години в Северното полукълбо, с изключение на хималайския район Хиндукуш, който не е изследван. Това предполага леко средно увеличение на емисиите въглероден диоксид. Ако въглеродните емисии бъдат намалени и глобалното затопляне и топене на ледовете се забави, масовото освобождаване на бактерии от тях ще се свие с една трета.
"Наблюдаваме как ледниците умират пред очите ни, което засяга микробите в тях, с последици за нас и локално, и глобално", каза д-р Аруин Едуардс от университета Абъристуит в Уелс, Великобритания.
До неотдавна се знаеше малко за хилядите видове микроби, обитаващи ледената повърхност. През юни на тибетски ледник бяха идентифицирани близо 1000 нови микробни вида.